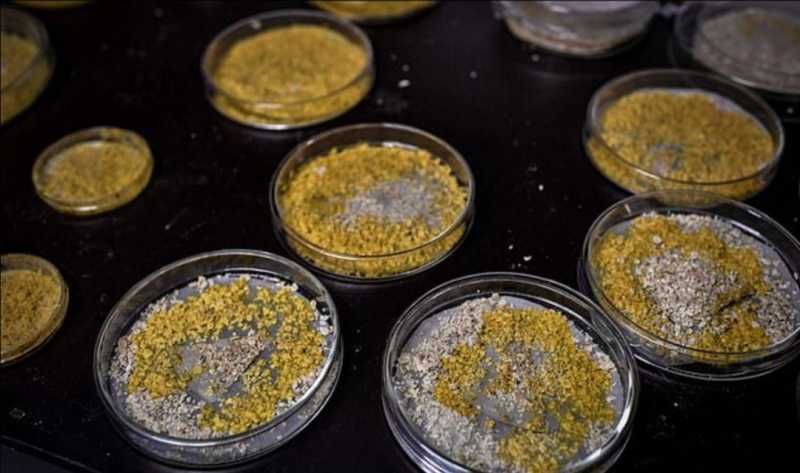

巴黎动物园展出“奇怪生物”,被砍断能自愈,还有720种性别

据说,它外形像菌类,行动起来却像动物,无脑却有智慧,能自愈,还有720种性别。
当地时间周三,法国巴黎动物园(Paris Zoological Park)向媒体展示了一种奇特的生物。

图 via CNN
这种生物外形呈鲜亮的黄色黏液状,被称为“粘液菌”(slime mold)或叫“多头粘液”(the many headed slime)。它看起来像菌类,却有着动物的行为能力。它没有腿或翅膀,却能以每小时4厘米的速度爬行。假如被一分为二,它能在两分钟内自愈。它不止有两种性别,而是有着多达720种性别(科学家们怎么知道的?)最神奇的是,它没有大脑,却会解决问题。

图 via Reuters
"It surprises us because it has no brain but is able to learn (...) and if you merge two blobs, the one that has learned will transmit its knowledge to the other," aid Bruno David, director of the Paris Museum of Natural History, of which the Zoological Park is part.
“这让我们很惊讶,因为它没有大脑,但却能学习……如果你把两个粘液菌团合并起来,那个已经学会的粘液菌团就会把它的‘知识’传递给另一个粘液菌团,”巴黎自然历史博物馆馆长布鲁诺·大卫说道。
Researchers say the organism, which has been loosely identified as some kind of slime mold, is capable of a learning.
研究人员说,这种曾被粗略地定义为某种粘液霉菌的生物具有学习能力。
In an experiment from 2016, researchers found that they could teach the mold to cross a bridge lined with salt - a substance the mold was initially repulsed by.
在2016年的一项实验中,研究人员发现他们可以教会粘液菌通过一座撒了盐(粘液菌最初排斥的物质)的桥。
Furthermore, they found that when they combined a slime mold with another mold that had not been taught to cross the bridge, the learning transferred into the new organism.
此外,他们还发现,当他们把一个粘液菌团与另一个没有学过过桥的粘液菌团结合起来时,那个已经学过的粘液菌会把它的所学传授给新的粘液菌。
▲Meet the Blob: Organism with no brain and almost 720 sexes that regenerates in TWO MINUTES after being cut in-half is showcased at Paris zoo (via Daily Mail)

图 via Reuters
科学家们相信,这种单细胞生物距今大约已经生存了10亿年。不过它首次引起公众注意还是在1973年。
It first came to public's attention in May 1973, after a Texas woman discovered a rapidly-expanding yellow blob growing in her backyard. With its otherworldly, extraterrestrial appearance, the blob became a brief media sensation, even picking up a mention in the New York Times.
它第一次引起公众的注意是在1973年5月,当时一名美国德克萨斯州的妇女在她的后院发现了一个正在迅速膨胀的黄色团块。凭借其超凡脱俗、天外来客的外形,这团粘液菌一度在媒体上引起轰动,甚至被《纽约时报》提及。
The Texas blob died as quickly as it had appeared.
德州那一团粘液菌出现得快,死得也快。
Scientists initially grew the blob in petri dishes, feeding it oatmeal, its favorite food, according to a video published by the Zoological Park. Once it had reached a certain size, it was grafted onto tree bark -- which it feeds on -- and placed in a terrarium, where visitors will be able to view it from October 19.
根据巴黎动物园发布的一段视频,科学家们最初在培养皿中培育了这团粘液菌,喂它最喜欢的食物——麦片。一旦长到一定的尺寸,它就被嫁接到了树皮上——树皮是它的食物来源——并被放置在一个玻璃容器内,从10月19日起,游客们就可以看到它了。
"Acacia trees, oak bark and chestnut bark are its favorite places," said the zoo's Marlene Itan.
“金合欢树、橡树皮和栗树皮是它最喜欢的地方,”巴黎动物园的玛琳·伊坦说道。
The blob is normally found on forest floors in Europe, she added. "It thrives in temperatures oscillating between 19 and 25 degrees Celsius (66 to 77 degrees Fahrenheit) and when humidity levels reach 80% to 100%," she said.
伊坦补充说,这种粘液菌通常出现在欧洲的森林地面上。“当温度在19到25摄氏度(66到77华氏度)之间波动,湿度达到80%到100%时,它就会茁壮成长,”伊坦说道。
Almost immortal, its only foes are light and drought, according to the zoo's press release. But it can hibernate during several years when threatened, it added.
根据动物园称,它几乎是不朽的,唯一的敌人是光照和干旱。但它可以在受到威胁时,冬眠好几年。
▲The 'blob': Paris zoo unveils unusual organism which can heal itself and has 720 sexes (via CNN)
图 via Getty Images
你觉得这种神奇的生物有趣吗?
整合:Du Qiongfang
资料:CNN, Daily Mail
图/题图:Reuters, Getty Images, CNN
下一篇:25种世界上最奇异的生物
大家都在看
-
大自然它是一只昆虫,却以雏鸟为食,可人们奇妙生物,如此... 你见过虫儿吃鸟吗?这只身披盔甲的蟋蟀竟然闯入鸟窝,想要吃掉刚出生的小鸟。我们只听说过早起的鸟儿有虫吃,却未曾见过早起的虫儿去吃鸟,可它却用实际行动给我们狠狠的上了一课。而它就是被誉为非洲瘟神的披甲蟋蟀 ... 奇异生物01-22
-
深海奇异生物大揭秘 深海,是地球上最神秘、最未被完全探索的区域之一。这里黑暗、寒冷、压力巨大,却孕育着各种奇异的生物。这些深海奇异生物以其奇特的外形、独特的生存策略,吸引了科学家和探险家的极大兴趣。今天,就让我们一同走进 ... 奇异生物01-22
-
山海经大荒西经揭秘:神话背后的荒蛮世界与奇异生物 #我要上头条##历史冷知识##历史古迹##山海经#《山海经》作为中华民族古代神话传说和地理志的瑰宝,记载了丰富的神祇、奇异生物以及神秘的地理景观。其中的“大荒西经”部分,带领我们穿越遥远的荒蛮之地,探索 ... 奇异生物01-13
-
石龙子:卵生策略,自然界的奇妙生物 石龙子:卵生策略。石龙子:卵生策略--环境适应的精妙博弈。石龙子,这一兼具胎生与卵生能力的独特蜥蜴,其卵生策略是自然选择下环境适应的精妙体现。在澳大利亚东海岸,从高海拔寒冷地区到低海拔温暖潮湿地带,多样 ... 奇异生物01-10
-
《山海经》热播,带你探索神话世界的奇异生物! 《山海经》热播。《山海经》这部上古奇书虽诞生于遥远的战国至汉代初期,却与现代社会有着诸多话题共鸣,展现出跨越时空的独特魅力。书中丰富的神话传说,如精卫填海、夸父逐日等,传递出的坚韧不拔、勇于探索的精神 ... 奇异生物01-09
-
神秘生物现身丛林,目击者反应惊人 简直难以置信,这是目击者在大山深处所拍到的一段十分罕见的场面。注意看,就在镜头前方大约百米开外的一处半山腰上,此时目击者的手机突然就拍到茂密的丛林里面居然出现了一个非常奇怪的不明生物。而当画面逐渐推进 ... 奇异生物01-07
-
20张奇怪的生物照:黄蜂把死去同伴叠在背上,狒狒绑架走小狮子 “骑摩托的鳄鱼”冲上热搜那天,我正挤在地铁里刷手机,差点笑到把旁边大叔的早餐撞飞——这画面太像《疯狂动物城》删掉的彩蛋。可笑着笑着就笑不出来了:评论区一水儿“东南亚日常”,好像野生动物天生就该被捆在后 ... 奇异生物01-05
-
探索水下世界,发现奇异生物 这是自然界中最凶残的软体生物巨型水蛭。别看它体长仅20厘米,却能在几分钟内猎杀体型大自己数倍的螃蟹。猎物一旦被它吸附便会彻底丧失反抗能力,只能眼睁睁看着自己的身体被一点点蚕食殆尽。作为水蛭家族中的" ... 奇异生物01-01
-
草坪堆里发出奇怪叫声,村民合力找出来一条2米长生物,咋办? 奶奶经过这里,听到这里有习惯的叫声,然后叫我们过来才发现这里有一条两米长的生物,还好把它夹到外面去了,现在已经放生了,安全了。这里房前屋后都住的有人,奶奶就住这里,还是蛮危险的。不过最后大家把它处理好 ... 奇异生物12-31
-
《阿凡达》里潘多拉星球的生物原型,会飞的水母到底是什么? 地球是一个奇迹文化|全球在影片中,美杜莎水母(Medusoid)及其他生物深受自然与野生动物的影响。| 国家地理图片集众所周知,知名导演、国家地理探险家詹姆斯·卡梅隆镜头下的奇幻星球潘多拉,既是地球的镜像缩影, ... 奇异生物12-28
相关文章
- 《阿凡达》里潘多拉星球的生物原型,会飞的水母到底是什么?
- 隐藏海底的奇异生物,对人类展开报复!奇幻英剧《陆海之战...
- 不明生物大揭秘,有你遇见过的吗?(第二段)
- 《山海经》中的奇异生物:是真实存在还是古人天马行空的幻想?
- 不明生物大揭秘,有你遇见过的吗?(第一段)
- 舌尖上的奇异生物,探秘未知的美味【Al生成】
- 事发辽宁海域,沙滩上密密麻麻地布满奇怪生物!赶海男子:“看起来像……”
- 大自然中的奇妙生物,你见过吗?
- 意外发现奇异生物!它们不属于已知生物的任何一个界
- 两个长相十分怪异的不明生物,紧紧的蜷缩着身体,在这里一...
- 雄性怀孕—奇异的海洋生物,你知道吗?
- 宇宙中的奇异生物,散发着神秘的光芒!
- 深山遇 “奇异生物”:老猎人的惊魂经历,告诫世人 “不贪、不扰”
- 深海探秘:那些你从未见过的奇异海底生物和神秘世界!
- 日本人把它当美食?渔民捞到奇异深海生物,酷似“外星人的头”
- 神奇动物图鉴:快来认识这些奇妙生物
- 放牛的大姐,居然在野外偏僻的芦苇荡里面,发现了奇怪的生物
- 小伙发现奇怪生物,结果丢掉了小命
- 美国水域惊现奇异生物,引发科学界热议
- 二百万
热门阅读
-
恐怖的触手怪,竟被日本当成了淫秽漫画作品的题材 07-11
-
平头哥是什么梗,不服就干的“社会人”形象 03-14
-
暹罗猫价格多少钱一只,最低仅需500元左右 08-12
-
高产水稻前十名的品种,连粳11号排第一名 10-19
-
哪种兰花最名贵?最名贵的10种兰花价格 10-21
-
十大仙草药排名:冬虫夏草上榜,铁皮石斛夺冠 11-07
